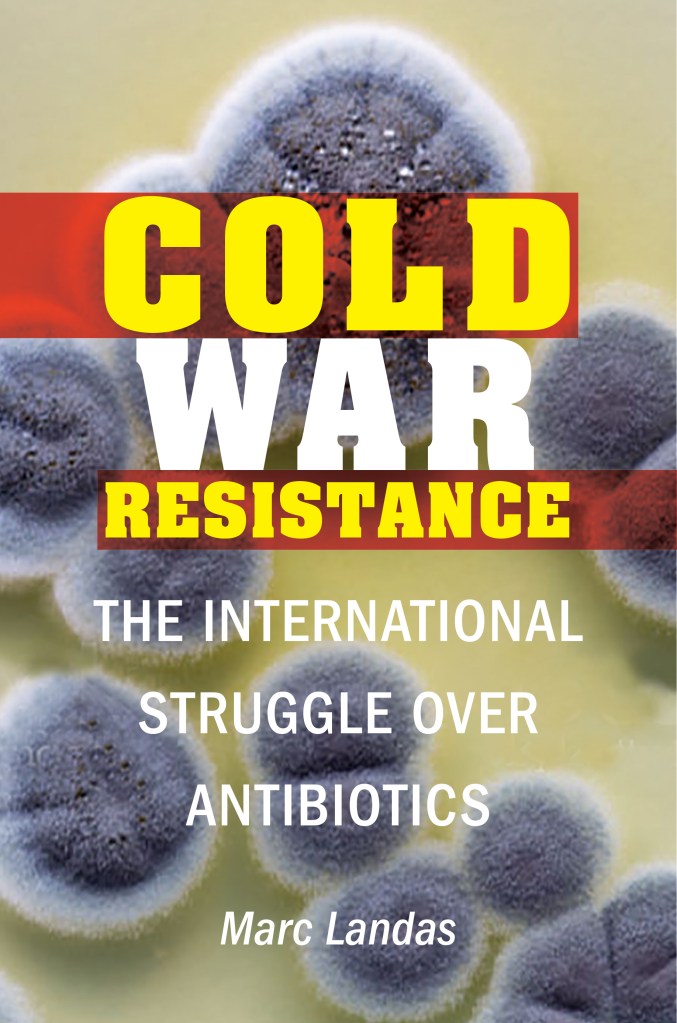

The following books will be available this Fall from Potomac Books!
The Mysteries of Haditha: A Memoir by M. C. Armstong
Fidelis: A Memoir by Teresa Fazio
More Stories from Langley: Another Glimpse inside the CIA edited and with an introduction by Edward Mickolus
Assignment: Pentagon: How to Excel in a Bureaucracy (Fifth Edition) by Maj. Gen. Perry M. Smith, USAF (Ret.) and Col. Daniel M. Gerstein, USA (Ret.)
Rage: Narcissism, Patriarchy, and the Culture of Terrorism by Abigail R. Esman
Cold War Resistance: The International Struggle over Antibiotics by Marc Landas
A Glorious Liberty: Frederick Douglass and the Fight for an Antislavery Constitution by Damon Root
Who Invented Oscar Wilde?: The Photograph at the Center of Modern American Copyright by David Newhoff
The Great Kosher Meat War of 1902: Immigrant Housewives and the Riots That Shook New York City by Scott D. Seligman
The Global Spread of Islamism and the Consequences for Terrorism by Michael Freeman with Katherine Ellena and Amina Kator-Mubarez
Gifted Greek: The Enigma of Andreas Papandreou by Monteagle Stearns
Emergency War Plan: The American Doomsday Machine, 1945-1960 by Sean M. Maloney
Call Me Commander: A Former Intelligence Officer and the Journalists Who Uncovered His Scheme to Fleece America by Jeff Testerman and Daniel M. Freed
And new in paperback:
Whiskey Women: The Untold Story of How Women Saved Bourbon, Scotch, and Irish Whiskey by Fred Minnick
Strategy Strikes Back: How Star Wars Explains Modern Military Conflict edited by Max Brooks, John Amble, ML Cavanaugh, and Jaym Gates
Winnie Davis: Daughter of the Lost Cause by Heath Hardage Lee